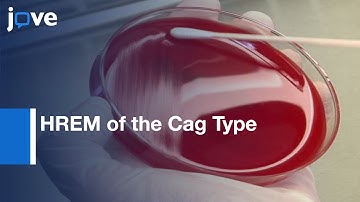
HREM of the Cag Type IV Secretion System Pili | Protocol Preview

⬇ DOWNLOAD NOW
Kalau muncul iklan pop-up, tutup lalu klik tombol kembali
Download lagu The first structure of a Type IV secretion system secara gratis hanya untuk keperluan promosi. Dukung artis favorit kamu dengan membeli musik original di iTunes atau platform resmi lainnya.
 The Type IV secretion system
The Type IV secretion system
 Type 4 Secretion System
Type 4 Secretion System
 Type 4 secretion
Type 4 secretion
 Type 4 secretion system: i- Assembly
Type 4 secretion system: i- Assembly
 Process of building a working model of the type IV pilus machine
Process of building a working model of the type IV pilus machine
 Type 4 secretion system: ii- Pilus biogenesis
Type 4 secretion system: ii- Pilus biogenesis
 Sheath contraction in a bacterial type VI secretion system
Sheath contraction in a bacterial type VI secretion system
HREM of the Cag Type IV Secretion System Pili | Protocol Preview
HREM of the Cag Type IV Secretion System Pili | Protocol Preview